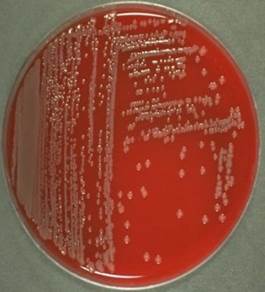

Bactéria
Vibrio parahaemolyticus
Pedro Henrique Soares dos Santos
Junho
2019
O que são
bactérias?
Bactérias são micro organismos constituídos por
uma única célula (unicelulares) procariontes pertencentes ao Reino Monera. Vale
lembrar que muitas bactérias não apresentam riscos ao ser humano, ao contrário,
são benéficas. Os probióticos, por exemplo, que de acordo com a definição da
OMS - Organização
Mundial de Saúde os define como “organismos vivos que, quando administrados em
quantidades adequadas, conferem benefício à saúde do hospedeiro”. Outros gêneros de bactérias, no entanto, fazem mal
ao ser humano, podendo causar de doenças como a Vibrio parahaemolyticus. As bactérias se movem
através de flagelos (batimento flagelar), e outros anexos como piliou fimbrias que
ajudam o deslocamento de material genético entre bactérias visando facilitar a
aderência a determinado organismo podendo causar infecções.
As bactérias podem se diferenciam de acordo com seu formato, sendo
eles:
Bacilos: Bactérias com formato de bastão
Cocos: Bactérias com formato esférico (fala-se: cócos)
O que é a bactéria Vibrio parahaemolyticus?
A
bactéria Vibrio parahaemolyticus é uma bactéria gram-negativa, do
tipo bacilo flagelado, sendo ela frequentemente encontrada em regiões marinhas
e estuários (zonas de encontro do rio com o mar), presente em frutos do mar e
pescados, podendo ser causadora de doenças e produtora de toxinas. É mais
vista durante os períodos mais quentes do ano. A espécie Vibrio
parahaemolyticus é umas das mais importantes bactérias veiculadas por alimentos
que se destaca pela ingestão, principalmente de ostras e mexilhões crus. Esta bactéria é comum em várias partes do mundo como
Japão, Sul da Ásia e EUA. A doença é causada quando a bactéria fixa no
intestino do individuo e solta uma toxina (ainda não identificada).
Figura 01 – Bactéria Vibrio parahaemolyticus
|
Descrição: a imagem exibe uma
cultura da bactéria Vibrio parahaemolyticus em uma
placa de Petri.
|
Fonte: Faculty of Health and Medical Sciences - University
of Copenhagen – Denmark, 2011.
|
O que são vibriões?
São um tipo de bactéria capaz de moverem-se,
possuindo uma forma de bastonete curvo, como células podem se ligar uma à
outra, formando a letra "S". São bacilos gram negativos
altamente móveis através de um único flagelo, não esporulados, sendo aeróbias
facultativas.
Como acontece a proliferação e o desenvolvimento da bactéria?
A temperatura ideal de proliferação da bactéria varia de 20 a 32°
C, podendo suportar até mesmo temperaturas maiores que 41°C. É halófila
(desenvolve-se em ambientes com altas concentrações de sal), incidindo
principalmente em moluscos bivalves ( animais que se alimentam de partículas
grandes). O micro organismo cresce em pH entre 4 e 8.
Figura
01 – Bactéria Vibrio parahaemolyticus
|
Descrição: a imagem exibe a
bactéria Vibrio parahaemolyticus em cores fictícias.
|
Fonte: Science Photo Library, 2019
|
Classificação Vibrio parahaemolyticus
A bactéria é uma das principais espécies do gênero Vibrio predominante
nas regiões costeiras de clima temperado e tropical em todo o mundo. A
capacidade do micro organismo em causar inflamações gastrointestinais sobre a
forma de surtos ou casos esporádicos ligados à ingestão de pescados e moluscos
bivalves mal cozidos acende o alerta para as autoridades sanitárias (órgãos
públicos que dentre outras funções, fiscalizam a venda de alimentos).
A doença
A doença de Gastroenterite está associada à infecção pela bactéria
Vibrio parahaemolyticus, sendo causada pelo consumo de alimentos contaminados
pelo micro organismo. Os sintomas mais frequentes são: diarreia com ou sem
sangue, cólicas abdominais, náuseas, vômitos, febre e calafrios. Este patógeno
(aquilo que causa doenças) pode causar também infecções em feridas. Em casos
mais severos, ocorre desidratação grave. Normalmente, a doença é leve ou
moderada, com raras exceções de infecções maiores.
Epidemiologia da doença
Casos e surtos pouco frequentes têm sido registrados em várias
partes do mundo como o Japão, Sul da Ásia e Estados Unidos, este último possui
uma maior quantidade de dados notificados: uma média de 45 mil infecções
anualmente. Das doenças causadas por contaminação de alimentos, a infecção por
Vibrio parahaemolyticus ocorre
raramente no Brasil, conforme a imagem abaixo:
Como evitar a contaminação pela doença?
A bactéria
Vibrio parahaemolyticus possui maior afinidade com ambientes
mais quentes. O armazenamento inadequado, a falta de assepsia (limpeza), o
consumo de peixe e frutos do mar crus, colaboram para a liberação de um
maior número de toxinas por parte das bactérias.
- § Higienize sempre os alimentos: use álcool ou alvejante (lembre-se
de lavar com água corrente depois);
- § Cozinhe os alimentos por no mínimo 15 minutos, depois de começar a
ferver;
- § Certifique-se da procedência (origem) dos mariscos e pescados;
- § Em caso do surgimento de quaisquer dos sintomas aqui abordados,
procure a ESF (Estratégia de Saúde da Família), mais próxima de sua casa.
Como é feito o diagnóstico
da doença?
![]() |
| Adicionar legenda |
Como é feito o tratamento?
O tratamento consiste na hidratação oral ou intravenosa e em casos
mais específicos, a/o médica/o costuma receitar antibióticos como a
Tetraciclina para combater à infecção.
A doença não é contagiosa, ou seja, não é possível
"pegar" uma infecção por Vibrio parahaemolyticus de
outra pessoa.
A província de Kanagawa no Japão é a região em que se identificou
inicialmente a bactéria. Por essa razão, o teste de Kanagawa, um importante
método de análise desse micro organismo, possui esse nome.
Em 2002, em um evento na cidade de Fortaleza/CE, após o servimento de "coffe break",
vários participantes queixaram-se de fortes dores abdominais, enjoos e de quadro de diarreia e foram encaminhados a um hospital. Após o trabalho da Vigilância Sanitária, identificou-se que eles haviam consumido mariscos contaminados por Vibrio parahaemolyticus. .
Em 2002, em um evento na cidade de Fortaleza/CE, após o servimento de "coffe break",
vários participantes queixaram-se de fortes dores abdominais, enjoos e de quadro de diarreia e foram encaminhados a um hospital. Após o trabalho da Vigilância Sanitária, identificou-se que eles haviam consumido mariscos contaminados por Vibrio parahaemolyticus. .
Referências
1.BRASIL. Boletim Eletrônico
Epidemiológico. Brasília: Ministério da Saúde, Centro Nacional de
Epidemiologia, FUNASA. Ano II,
n. 4, dez. 2002. Acesso em: 29 jun. 2019.
2.CENTERS
FOR DISEASE CONTROL AND PREVENTION. Vibrio Species Causing Vibriosis. Disponível em: <https://www.cdc.gov/vibrio/index.html>.
Acesso em: 29 jun. 2019.
3.FDA/CFSAN. Bad Bug Book. Vibrio
parahaemolyticus.Disponível em: <http://www.fda.gov/Food/FoodborneIllnessContaminants/CausesOfIllnessBadBugBook/default.htm>.Acesso em: 28 de junho de 2019.
4.MINISTÉRIO DA SAÚDE. Doenças Transmitidas por
Alimentos. Disponível em: <http://portalarquivos2.saude.gov.br/images/pdf/2015/outubro/19/Apresenta----o-dados-gerais-DTA-2015.pdf>.
Acesso em: 30 jun. 2019.
5.PEREIRA, C. S. et al. Características de
Vibrio parahaemolyticus isolados de mexilhões (Perna perna) comercializados em
Niterói, Rio de Janeiro. Revista da Sociedade Brasileira de Medicina
Tropical, Brasília, v. 40, n. 1, p. 56-59, jan-fev.2007.
6.WIKIPÉDIA. Vibrio parahemolyticus. Disponível em: <https://pt.wikipedia.org/wiki/Vibrio_parahemolyticus>.
Acesso em: 28 jun. 2019.
Créditos de Imagens
Todas as
imagens cujas fontes não foram citadas ao longo do texto, tiveram seus direitos
autorais foram preservados. Fonte: Google Images.

Está muito bem explicado, perfeitoooo
ResponderExcluirMeu ajudou muito no meu trabalho como vendedor de mariscos em Nova Viçosa
ResponderExcluirAmeii!! Excelente trabalho. Leitura clara e coesa, além de um layout bem organizado.
ResponderExcluirAmeii!! Excelente trabalho. Leitura clara e coesa, além de um layout bem organizado.
ResponderExcluirNossa, tudo tão bem explicado... parabéns ao responsável! Me ajudou bastante a entender sobre esta doença.
ResponderExcluirO universo da microbiologia é fantástico! E com este material fica ainda mais interessante estudar este ramo da biologia. Parabéns, Pedro!!! Sucesso!!!
ResponderExcluirInformação é tudo! Parabéns por levar conhecimento de qualidade a sociedade!
ResponderExcluirMuito útil!!!
ResponderExcluirShow. Muito bem explicado! Gostei de como foi explicado como evitar a contaminação e das curiosidades ;)
ResponderExcluirAmei! Ótimo trabalho!!! E de quebra assunto da próxima prova! Grata! E muito sucesso em sua jornada!!! Estamos com vc!<3
ResponderExcluirLinguagem acessível,conteúdos bem organizados e boa sequencia de ideias. Show!
ResponderExcluir